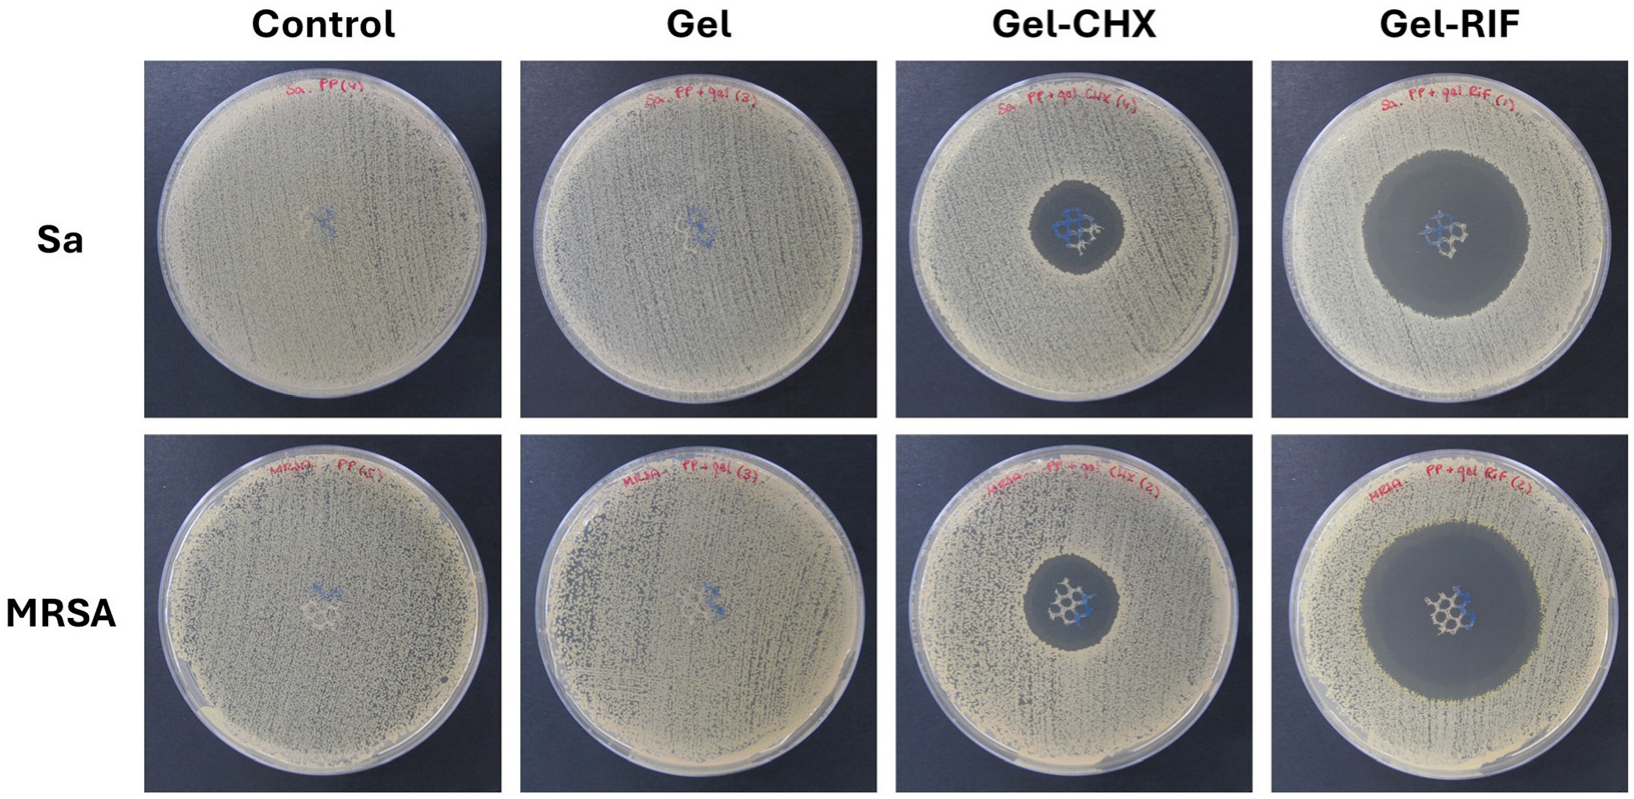
Gels 10 00687 g002

Potentiality of Antibacterial Gels for the Prophylactic Coating of Hernia Repair Prosthetic Materials
Abstract
:1. Introduction
2. Results and Discussion
2.1. Solubility of Antimicrobials in the CMC Gel
2.2. Spectral and Morphological Characterization of the Gels
2.3. Gel Flow Time
2.4. Performance of Gels as Coating Compounds for PP Meshes
2.5. Control of the Bacterial Inocula
2.6. Antibacterial and Biocide Performance of the Gel-Based Coatings
2.7. Usefulness of the Gel Coatings to Prevent Bacterial Adhesion to the Mesh Surface
2.8. Cytocompatibility
2.9. Limitations and Future Perspectives on the Use of Gel-Based Coatings for Devices
3. Conclusions
4. Materials and Methods
4.1. Chemicals
4.2. Elaboration of the Gels
4.3. Spectral Characterization of the Formulated Gels and Determination of Drug Content
4.4. Monitoring of the Flow Time
4.5. Mesh Material
4.6. Coating the of Meshes and Establishment of the Study Groups
- Control: Uncoated PP meshes.
- Gel: PP meshes coated with unloaded gel.
- Gel-CHX: PP meshes coated with 0.05% CHX-loaded gel.
- Gel-RIF: PP meshes coated with 0.13 mg/mL RIF-loaded gel.
4.7. Surface Characterization of the Coated Meshes
4.8. Bacterial Strains
4.9. Agar Diffusion Test
4.10. Turbidimetry
4.11. Sonication
4.12. Crystal Violet Staining
4.13. Scanning Electron Microscopy (SEM)
4.14. Cell Viability
4.15. Statistical Analysis
Author Contributions
Funding
Institutional Review Board Statement
Informed Consent Statement
Data Availability Statement
Acknowledgments
Conflicts of Interest
References
- HerniaSurge Group. International guidelines for groin hernia management. Hernia 2018, 22, 1–165. [Google Scholar] [CrossRef] [PubMed]
- Lockhart, K.; Dunn, D.; Teo, S.; Ng, J.Y.; Dhillon, M.; Teo, E.; van Driel, M.L. Mesh versus non-mesh for inguinal and femoral hernia repair. Cochrane Database Syst. Rev. 2018, 9, CD011517. [Google Scholar] [CrossRef] [PubMed]
- Russo Serafini, M.; Medeiros Savi, F.; Ren, J.; Bas, O.; O’Rourke, N.; Maher, C.; Hutmacher, D.W. The patenting and technological trends in hernia mesh implants. Tissue Eng. Part B Rev. 2021, 27, 48–73. [Google Scholar] [CrossRef] [PubMed]
- Pande, T.; Naidu, C.S. Mesh infection in cases of polypropylene mesh hernioplasty. Hernia 2020, 24, 849–856. [Google Scholar] [CrossRef]
- Bueno-Lledó, J.; Torregrosa-Gallud, A.; Carreño-Saénz, O.; García-Pastor, P.; Carbonell-Tatay, F.; Bonafé-Diana, S.; Iserte-Hernández, J. Partial versus complete removal of the infected mesh after abdominal wall hernia repair. Am. J. Surg. 2017, 214, 47–52. [Google Scholar] [CrossRef]
- Sakamoto, T.; Fujiogi, M.; Ishimaru, M.; Matsui, H.; Fushimi, K.; Yasunaga, H. Comparison of postoperative infection after emergency inguinal hernia surgery with enterectomy between mesh repair and non-mesh repair: A national database analysis. Hernia 2022, 26, 217–223. [Google Scholar] [CrossRef]
- Engelsman, A.F.; van Dam, G.M.; van der Mei, H.C.; Busscher, H.J.; Ploeg, R.J. In vivo evaluation of bacterial infection involving morphologically different surgical meshes. Ann. Surg. 2010, 251, 133–137. [Google Scholar] [CrossRef]
- Zimmermann, C.; Troeltzsch, D.; Giménez-Rivera, V.A.; Galli, S.J.; Metz, M.; Maurer, M.; Siebenhaar, F. Mast cells are critical for controlling the bacterial burden and the healing of infected wounds. Proc. Natl. Acad. Sci. USA 2019, 116, 20500–20504. [Google Scholar] [CrossRef]
- Keric, N.; Campbell, A. Meshing around: High-risk hernias and infected mesh. Trauma Surg. Acute Care Open 2024, 9, e001379. [Google Scholar] [CrossRef]
- Tubre, D.J.; Schroeder, A.D.; Estes, J.; Eisenga, J.; Fitzgibbons, R.J., Jr. Surgical site infection: The “Achilles Heel” of all types of abdominal wall hernia reconstruction. Hernia 2018, 22, 1003–1013. [Google Scholar] [CrossRef]
- Wilson, R.B.; Farooque, Y. Risks and prevention of surgical site infection after hernia mesh repair and the predictive utility of ACS-NSQIP. J. Gastrointest. Surg. 2022, 26, 950–964. [Google Scholar] [CrossRef] [PubMed]
- Delaplain, P.T.; Kaafarani, H.M.A.; Benedict, L.A.O.; Guidry, C.A.; Kim, D.; Loor, M.M.; Machado-Aranda, D.; Mele, T.S.; Mendoza, A.E.; Morris-Stiff, G.; et al. Scientific Studies Committee of the Surgical Infection Society. Different surgeon, different duration: Lack of consensus on the appropriate duration of antimicrobial prophylaxis and therapy in surgical practice. Surg. Infect. 2022, 23, 232–247. [Google Scholar] [CrossRef] [PubMed]
- Birolini, C.; Faro Junior, M.P.; Terhoch, C.B.; de Miranda, J.S.; Tanaka, E.Y.; Utiyama, E.M. Microbiology of chronic mesh infection. Hernia 2023, 27, 1017–1023. [Google Scholar] [CrossRef] [PubMed]
- Rahman, M.S.; Hasan, M.S.; Nitai, A.S.; Nam, S.; Karmakar, A.K.; Ahsan, M.S.; Shiddiky, M.J.A.; Ahmed, M.B. Recent developments of carboxymethyl cellulose. Polymers 2021, 13, 1345. [Google Scholar] [CrossRef] [PubMed]
- Allen, L.V., Jr. Chlorhexidine digluconate 0.05% in normal saline bladder irrigation. US Pharm. 2017, 42, 47–48. [Google Scholar]
- Muneeswaran, Z.P.; Teoman, B.; Wang, Y.; Chaudhry, H.; Brinzari, T.V.; Verma, G.; Ranasinghe, L.; Kaler, K.R.; Huang, X.; He, X.; et al. Novel anionic surfactant-modified chlorhexidine and its potent antimicrobial properties. Dalton Trans. 2024, 53, 2670–2677. [Google Scholar] [CrossRef]
- Ribeiro, A.C.; Rocha, Â.; Soares, R.M.D.; Fonseca, L.P.; da Silveira, N.P. Synthesis and characterization of acetylated amylose and development of inclusion complexes with rifampicin. Carbohydr. Polym. 2017, 157, 267–274. [Google Scholar] [CrossRef]
- Pandya, S.R.; Singh, M. Dispersion and optical activities of newly synthesized magnetic nanoparticles with organic acids and dendrimers in DMSO studied with UV/vis spectrophotometry. J. Mol. Liq. 2015, 211, 146–156. [Google Scholar] [CrossRef]
- Ostergard, D.R. Degradation, infection and heat effects on polypropylene mesh for pelvic implantation: What was known and when it was known. Int. Urogynecol. J. 2011, 22, 771–774. [Google Scholar] [CrossRef]
- Mu, M.; Liu, S.; DeFlorio, W.; Hao, L.; Wang, X.; Salazar, K.S.; Taylor, M.; Castillo, A.; Cisneros-Zevallos, L.; Oh, J.K.; et al. Influence of Surface Roughness, Nanostructure, and Wetting on Bacterial Adhesion. Langmuir 2023, 39, 5426–5439. [Google Scholar] [CrossRef]
- Yaşar, F.; Toğrul, H.; Arslan, N. Flow properties of cellulose and carboxymethyl cellulose from orange peel. J. Food Eng. 2007, 81, 187–199. [Google Scholar] [CrossRef]
- Rodríguez, M.; Gómez-Gil, V.; Pérez-Köhler, B.; Pascual, G.; Bellón, J.M. Polymer hernia repair materials: Adapting to patient needs and surgical techniques. Materials 2021, 14, 2790. [Google Scholar] [CrossRef] [PubMed]
- Toews, P.; Bates, J. Influence of drug and polymer molecular weight on release kinetics from HEMA and HPMA hydrogels. Sci. Rep. 2023, 13, 16685. [Google Scholar] [CrossRef] [PubMed]
- Hintze-Brüning, H.; Borgholte, H. Coating of untreated polypropylene with halogen free aqueous materials. Prog. Org. Coat. 2000, 40, 49–54. [Google Scholar] [CrossRef]
- Rahman, K.M.T.; Butzin, N.C. Counter-on-chip for bacterial cell quantification, growth, and live-dead estimations. Sci. Rep. 2024, 14, 782. [Google Scholar] [CrossRef]
- Hwang, J.H.; Lee, S.Y.; Choi, J. Microscopic analysis of bacterial inoculum effect using micropatterned biochip. Antibiotics 2021, 10, 300. [Google Scholar] [CrossRef]
- Balouiri, M.; Sadiki, M.; Ibnsouda, S.K. Methods for in vitro evaluating antimicrobial activity: A review. J. Pharm. Anal. 2016, 6, 71–79. [Google Scholar] [CrossRef]
- Mosaei, H.; Zenkin, N. Inhibition of RNA polymerase by rifampicin and rifamycin-like molecules. EcoSal Plus 2020, 9, 1110–1128. [Google Scholar] [CrossRef]
- Hardie, K.R.; Fenn, S.J. JMM profile: Rifampicin: A broad-spectrum antibiotic. J. Med. Microbiol. 2022, 71, 001566. [Google Scholar] [CrossRef]
- Baus-Domínguez, M.; Aguilera, F.R.; Vivancos-Cuadras, F.; Ferra-Domingo, L.; Torres-Lagares, D.; Gutiérrez-Pérez, J.L.; Pereira-Riveros, T.; Vinuesa, T.; Serrera-Figallo, M.Á. Mucoadhesive pharmacology: Latest clinical technology in antiseptic gels. Gels 2023, 10, 23. [Google Scholar] [CrossRef]
- Williamson, D.A.; Carter, G.P.; Howden, B.P. Current and emerging topical antibacterials and antiseptics: Agents, action, and resistance patterns. Clin. Microbiol. Rev. 2017, 30, 827e60. [Google Scholar] [CrossRef] [PubMed]
- Zimmerli, W.; Sendi, P. Role of rifampin against staphylococcal biofilm infections in vitro, in animal models, and in orthopedic-device-related infections. Antimicrob. Agents Chemother. 2019, 63, e01746-18. [Google Scholar] [CrossRef] [PubMed]
- Solderer, A.; Kaufmann, M.; Hofer, D.; Wiedemeier, D.; Attin, T.; Schmidlin, P.R. Efficacy of chlorhexidine rinses after periodontal or implant surgery: A systematic review. Clin. Oral Investig. 2019, 23, 21–32. [Google Scholar] [CrossRef]
- Pankey, G.A.; Sabath, L.D. Clinical relevance of bacteriostatic versus bactericidal mechanisms of action in the treatment of Gram-positive bacterial infections. Clin. Infect. Dis. 2004, 38, 864–870. [Google Scholar] [CrossRef]
- Tychala, A.; Protonotariou, E.; Meletis, G.; Tsoha, A.; Mantzana, P.; Vasilaki, O.; Kagkalou, G.; Skoura, L. In vitro activity of ceftaroline against methicillin-resistant and methicillin-susceptible Staphylococcus aureus clinical isolates from a tertiary hospital in Greece. New Microbiol. 2021, 44, 125–128. [Google Scholar]
- Min, K.; Kim, E.K.; Han, H.H.; Eom, J.S. The effect of intraoperative immersion solutions on acellular dermal matrix: Biofilm formation and mechanical property. J. Plast. Reconstr. Aesthet. Surg. 2023, 84, 191–202. [Google Scholar] [CrossRef]
- Esteban, P.; Redrado, S.; Comas, L.; Domingo, M.P.; Millán-Lou, M.I.; Seral, C.; Algarate, S.; Lopez, C.; Rezusta, A.; Pardo, J.; et al. In vitro and in vivo antibacterial activity of gliotoxin alone and in combination with antibiotics against Staphylococcus aureus. Toxins 2021, 13, 85. [Google Scholar] [CrossRef]
- Sanders, D.L.; Kingsnorth, A.N.; Lambie, J.; Bond, P.; Moate, R.; Steer, J.A. An experimental study exploring the relationship between the size of bacterial inoculum and bacterial adherence to prosthetic mesh. Surg. Endosc. 2013, 27, 978–985. [Google Scholar] [CrossRef]
- Bansal, D.; Khatri, K.; Dahuja, A.; Lakhani, A.; Malhotra, N. Comparison between vancomycin and gentamicin for intraoperative presoaking of hamstring graft in primary anterior cruciate ligament reconstruction. Cureus 2022, 14, e22550. [Google Scholar] [CrossRef]
- Adkins, J.M.; Ahmar, R.A.; Yu, H.D.; Musick, S.T.; Alberico, A.M. Comparison of antimicrobial activity between bacitracin-soaked sutures and triclosan coated suture. J. Surg. Res. 2022, 270, 203–207. [Google Scholar] [CrossRef]
- Xu, L.C.; Wo, Y.; Meyerhoff, M.E.; Siedlecki, C.A. Inhibition of bacterial adhesion and biofilm formation by dual functional textured and nitric oxide releasing surfaces. Acta Biomater. 2017, 51, 53–65. [Google Scholar] [CrossRef] [PubMed]
- Kreve, S.; Reis, A.C.D. Bacterial adhesion to biomaterials: What regulates this attachment? A review. Jpn. Dent. Sci. Rev. 2021, 57, 85–96. [Google Scholar] [CrossRef] [PubMed]
- Li, P.; Yin, R.; Cheng, J.; Lin, J. Bacterial biofilm formation on biomaterials and approaches to its treatment and prevention. Int. J. Mol. Sci. 2023, 24, 11680. [Google Scholar] [CrossRef]
- Sadava, E.E.; Krpata, D.M.; Gao, Y.; Novitsky, Y.W.; Rosen, M.J. Does presoaking synthetic mesh in antibiotic solution reduce mesh infections? An experimental study. J. Gastrointest. Surg. 2013, 17, 562–568. [Google Scholar] [CrossRef]
- Bontekoning, N.; Huizing, N.J.; Timmer, A.S.; Groenen, H.; de Jonge, S.W.; Boermeester, M.A. Topical antimicrobial treatment of mesh for the reduction of surgical site infections after hernia repair: A systematic review and meta-analysis. Hernia 2024, 28, 691–700. [Google Scholar] [CrossRef]
- Pérez-Köhler, B.; Linardi, F.; Pascual, G.; Bellón, J.M.; Eglin, D.; Guillaume, O. Efficacy of antimicrobial agents delivered to hernia meshes using an adaptable thermo-responsive hyaluronic acid-based coating. Hernia 2020, 24, 1201–1210. [Google Scholar] [CrossRef]
- Harth, K.C.; Rosen, M.J.M.; Thatiparti, T.R.; Jacobs, M.R.; Halaweish, I.; Bajaksouzian, S.; Furlan, J.; von Recum, H.A. Antibiotic-releasing mesh coating to reduce prosthetic sepsis: An in vivo study. J. Surg. Res. 2010, 163, 337–343. [Google Scholar] [CrossRef]
- Kanikireddy, V.; Varaprasad, K.; Jayaramudu, T.; Karthikeyan, C.; Sadiku, R. Carboxymethyl cellulose-based materials for infection control and wound healing: A review. Int. J. Biol. Macromol. 2020, 164, 963–975. [Google Scholar] [CrossRef]
- ISO 10993-5:2009; Biological Evaluation Of Medical Devices. Part 5: Tests For In Vitro Cytotoxicity. International Standard Organization: Geneva, Switzerland, 2009. Available online: https://www.iso.org/standard/36406.html (accessed on 20 May 2024).
- Hidalgo, E.; Dominguez, C. Mechanisms underlying chlorhexidine-induced cytotoxicity. Toxicol In Vitro 2001, 15, 271–276. [Google Scholar] [CrossRef]
- Macías, J.H.; Álvarez, M.F.; Arreguín, V.; Muñoz, J.M.; Macías, A.E.; Álvarez, J.A. Chlorhexidine avoids skin bacteria recolonization more than triclosan. Am. J. Infect. Control 2016, 44, 1530–1534. [Google Scholar] [CrossRef]
- Harrell, A.G.; Novitsky, Y.W.; Kercher, K.W.; Foster, M.; Burns, J.M.; Kuwada, T.S. In vitro infectability of prosthetic mesh by methicillin-resistant Staphylococcus aureus. Hernia 2006, 10, 120–124. [Google Scholar] [CrossRef] [PubMed]
- Robinson, J.; Sulzer, J.K.; Motz, B.; Baker, E.H.; Martinie, J.B.; Vrochides, D.; Iannitti, D.A. Long-term clinical outcomes of an antibiotic-coated non-cross-linked porcine acellular dermal graft for abdominal wall reconstruction for high-risk and contaminated wounds. Am. Surg. 2022, 88, 1988–1995. [Google Scholar] [CrossRef] [PubMed]
- Yabanoğlu, H.; Arer, İ.M.; Çalıskan, K. The effect of the use of synthetic mesh soaked in antibiotic solution on the rate of graft infection in ventral hernias: A prospective ran-domized study. Int. Surg. 2015, 100, 1040–1047. [Google Scholar] [CrossRef]
- Darouiche, R.O. Device-associated infections: A macroproblem that starts with microadherence. Clin. Infect. Dis. 2001, 33, 1567–1572. [Google Scholar] [CrossRef]
- ISO 2431:2019; Paints and Varnishes Determination of Flow Time by Use of Flow Cups. International Standard Organization: Geneva, Switzerland, 2019. Available online: https://www.iso.org/standard/73851.html (accessed on 17 September 2024).
- Pascual, G.; Pérez-Köhler, B.; Rodríguez, M.; Sotomayor, S.; Bellón, J.M. Postimplantation host tissue response and biodegradation of biologic versus polymer meshes implanted in an intraperitoneal position. Surg. Endosc. 2014, 28, 559–569. [Google Scholar] [CrossRef]

| Inoculum | S. aureus (Sa) | MRSA |
|---|---|---|
| #1 | 2.13 × 106 | 2.13 × 106 |
| #2 | 1.51 × 106 | 1.88 × 106 |
| #3 | 2.17 × 106 | 2.03 × 106 |
| #4 | 1.79 × 106 | 1.98 × 106 |
| #5 | 1.94 × 106 | 2.01 × 106 |
| Bacterial Strain | PP | Gel | Gel-CHX | Gel-RIF |
|---|---|---|---|---|
| S. aureus (Sa) | 0 | 0 | 23.33 ± 0.51 (2) | 41.78 ± 0.24 (1) |
| MRSA | 0 | 0 | 24.54 ± 0.09 (3) | 43.49 ± 0.31 |
| Bacterial Strain | Value | Control (1)(3) | Gel (2)(3) | Gel-CHX | Gel-RIF |
|---|---|---|---|---|---|
| S. aureus (Sa) | Minimum | 1.120 × 107 | 3.420 × 106 | 0 | 0 |
| Maximum | 1.680 × 108 | 1.620 × 107 | 0 | 0 | |
| Mean | 4.306 × 107 | 9.180 × 106 | 0 | 0 | |
| SD | 6.985 × 107 | 5.023 × 106 | 0 | 0 | |
| Error of mean | 3.124 × 107 | 2.246 × 106 | 0 | 0 | |
| MRSA | Minimum | 1.700 × 105 | 1.610 × 105 | 0 | 0 |
| Maximum | 9.170 × 105 | 3.170 × 105 | 0 | 0 | |
| Mean | 4.274 × 105 | 2.184 × 105 | 0 | 0 | |
| SD | 2.878 × 105 | 5.967 × 104 | 0 | 0 | |
| Error of mean | 1.287 × 105 | 2.669 × 104 | 0 | 0 |
| Cell Type | PP | Gel | Gel-CHX | Gel-RIF | DMSO |
|---|---|---|---|---|---|
| Fb | 96.44 ± 1.38 (1) | 92.49 ± 2.40 (1) | 72.55 ± 1.27 (2) | 91.04 ± 2.79 | 19.17 ± 2.97 (3) |
| MC | 96.80 ± 1.37 (1) | 94.95 ± 3.92 (1) | 66.53 ± 1.14 (2) | 90.42 ± 0.79 | 17.63 ± 3.50 (3) |
Disclaimer/Publisher’s Note: The statements, opinions and data contained in all publications are solely those of the individual author(s) and contributor(s) and not of MDPI and/or the editor(s). MDPI and/or the editor(s) disclaim responsibility for any injury to people or property resulting from any ideas, methods, instructions or products referred to in the content. |
© 2024 by the authors. Licensee MDPI, Basel, Switzerland. This article is an open access article distributed under the terms and conditions of the Creative Commons Attribution (CC BY) license (https://creativecommons.org/licenses/by/4.0/).
Share and Cite
Pérez-Köhler, B.; Benito-Martínez, S.; Rivas-Santos, C.; Gómez-Gil, V.; García-Moreno, F.; Pascual, G. Potentiality of Antibacterial Gels for the Prophylactic Coating of Hernia Repair Prosthetic Materials. Gels 2024, 10, 687. https://doi.org/10.3390/gels10110687
Pérez-Köhler B, Benito-Martínez S, Rivas-Santos C, Gómez-Gil V, García-Moreno F, Pascual G. Potentiality of Antibacterial Gels for the Prophylactic Coating of Hernia Repair Prosthetic Materials. Gels. 2024; 10(11):687. https://doi.org/10.3390/gels10110687
Chicago/Turabian StylePérez-Köhler, Bárbara, Selma Benito-Martínez, Celia Rivas-Santos, Verónica Gómez-Gil, Francisca García-Moreno, and Gemma Pascual. 2024. "Potentiality of Antibacterial Gels for the Prophylactic Coating of Hernia Repair Prosthetic Materials" Gels 10, no. 11: 687. https://doi.org/10.3390/gels10110687
APA StylePérez-Köhler, B., Benito-Martínez, S., Rivas-Santos, C., Gómez-Gil, V., García-Moreno, F., & Pascual, G. (2024). Potentiality of Antibacterial Gels for the Prophylactic Coating of Hernia Repair Prosthetic Materials. Gels, 10(11), 687. https://doi.org/10.3390/gels10110687








